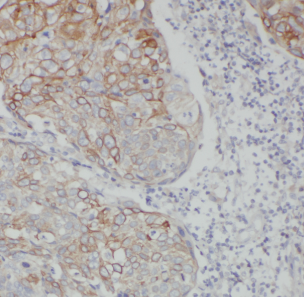

| 免疫原 | carcinoembryonic antigen-related cell adhesion molecule 5 |
| 亚型 | IgG |
| 形态 | liquid |
| 保存条件 | PBS with 0.02% sodium azide and 50% glycerol pH 7.3,-20℃ for 12 months(Avoid repeated freeze / thaw cycles.) |
| 克隆性 | 多克隆 |
| 适应物种 | Human |
| 保质期 | 12 months -20℃ |
| 抗原来源 | carcinoembryonic antigen-related cell adhesion molecule 5 |
| 目录编号 | FNab01576 |
| 级别 | 科研 |
| 数量 | 100 |
| 供应商 | 武汉菲恩生物科技有限公司 |
| 宿主 | Rabbit |
| 应用范围 | ELISA, IHC |
| 抗体英文名 | anti- CEA antibody |
| 抗体名 | anti- CEA antibody |
| 规格 | 100µg |

| 产品名称 | anti- CEA antibody | |
|---|---|---|
| 货号 | FNab01576 | |
| 规格 | 100µg | |
| 纯化方法 | Immunogen affinity purified | |
| 纯度 | ≥95% as determined by SDS-PAGE | |
| 宿主 | Rabbit | |
| 克隆性 | polyclonal | |
| 亚型 | IgG | |
| 存储 | PBS with 0.02% sodium azide and 50% glycerol pH 7.3,-20℃ for 12 months(Avoid repeated freeze / thaw cycles.) | |
| 免疫原 | carcinoembryonic antigen-related cell adhesion molecule 5 | |
| 分子量 | ||
| Uniprot ID | P06731 | |
| 适用种属 | Human | |
| 验证应用 | ELISA, IHC | |
| 建议稀释比例 | IHC: 1:20-1:200 | |
| 图片 | | Immunohistochemistry of paraffin-embedded human colon cancer using FNab01576(CEA antibody) at dilution of 1:50 |
 | ||
| 注意事项 | CEA antibody|CEA抗体仅供科研使用 | |
